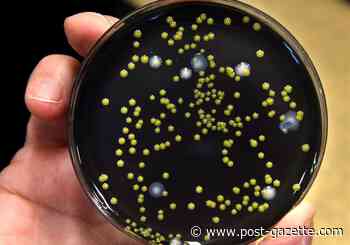
Legionnaires' case prompts cautious county to test water

✗ Close categories
 Ice Bucket Challenge
Ice Bucket Challenge
 Animals
Animals
 Apple
Apple
 Apps & Smartphones
Apps & Smartphones
 Artificial Intelligence
Artificial Intelligence
 Arts
Arts
 AT&T Inc.
AT&T Inc.
 Bank of America
Bank of America
 Berkshire Hathaway
Berkshire Hathaway
 Business
Business
 Cardinal Health Inc
Cardinal Health Inc
 Cars
Cars
 Celebrity
Celebrity
 Chevron Corporation
Chevron Corporation
 Child Care
Child Care
 Christian News
Christian News
 Christian Videos
Christian Videos
 Chrysler Group
Chrysler Group
 Citigroup
Citigroup
 ConocoPhillips Company
ConocoPhillips Company
 Conspiracy Channels
Conspiracy Channels
 Conspiracy theories
Conspiracy theories
 Conspiracy Videos
Conspiracy Videos
 Consumer
Consumer
 Cooking & Recipes
Cooking & Recipes
 Coronavirus
Coronavirus
 Costco Wholesale Corporation
Costco Wholesale Corporation
 Craigslist Inc.
Craigslist Inc.
 Cryptocurrency
Cryptocurrency
 Culture & Media
Culture & Media
 CVS Caremark Corporation
CVS Caremark Corporation
 Dance music & news
Dance music & news
 DIY
DIY
 Ebola
Ebola
 Electronics
Electronics
 Entertainment
Entertainment
 Exploding Kittens
Exploding Kittens
 Express- Scripts- Holding- Company
Express- Scripts- Holding- Company
 Exxon Mobil Corporation
Exxon Mobil Corporation
 Facebook Inc.
Facebook Inc.
 Fashion
Fashion
 Federal National Mortgage Assocation
Federal National Mortgage Assocation
 Films/Movies & reviews
Films/Movies & reviews
 Finance
Finance
 Flat Earth News
Flat Earth News
 Food
Food
 Ford Motor Company
Ford Motor Company
 Funny videos
Funny videos
 Gadgets
Gadgets
 games
games
 General Electric Company
General Electric Company
 General Motors
General Motors
 General News
General News
 Google Inc.
Google Inc.
 Gossip news
Gossip news
 Gourmet
Gourmet
 Gulden
Gulden
 Health
Health
 Hewlett-Packard Company
Hewlett-Packard Company
 Home
Home
 ID&T
ID&T
 International Business Machines Corporation
International Business Machines Corporation
 International Crime
International Crime
 JPMorgan Chase & Co
JPMorgan Chase & Co
 Kepler-186f planet
Kepler-186f planet
 Leisure time
Leisure time
 Leisure trends
Leisure trends
 Life & Style
Life & Style
 Literature
Literature
 Maranon Hammocks
Maranon Hammocks
 Marathon Petroleum Corporation
Marathon Petroleum Corporation
 McDonald's
McDonald's
 McKesson Corporation
McKesson Corporation
 Medical
Medical
 Microsoft Corporation
Microsoft Corporation
 Movies
Movies
 Music
Music
 News videos
News videos
 Obituaries
Obituaries
 Olympic Games
Olympic Games
 Organic food
Organic food
 Politics
Politics
 Quantum Computing
Quantum Computing
 Reddit
Reddit
 Royal Dutch Shell
Royal Dutch Shell
 Sci-Tech
Sci-Tech
 Social media
Social media
 social media news
social media news
 Technology
Technology
 Television
Television
 The Kroger Company
The Kroger Company
 The Walking Dead
The Walking Dead
 Top 25 Zoos
Top 25 Zoos
 Top10 twitter accounts
Top10 twitter accounts
 Traffic
Traffic
 Travel
Travel
 Twitter Inc
Twitter Inc
 UFO News and more
UFO News and more
 US Elections
US Elections
 Vacancies
Vacancies
 Valero Energy Corporation
Valero Energy Corporation
 Verizon Communications Inc.
Verizon Communications Inc.
 Virtual & Augmented Reality
Virtual & Augmented Reality
 Walmart
Walmart
 Weather
Weather
 Web design
Web design
 White House
White House
 Woman - Best beauty products & news
Woman - Best beauty products & news
 Woman - Feminism & world's most powerful women
Woman - Feminism & world's most powerful women
 Woman - Food & recipes
Woman - Food & recipes
 Woman - Hair ideas & tips
Woman - Hair ideas & tips
 Woman - Interior & assecoires
Woman - Interior & assecoires
 Woman - Latest fashion trends
Woman - Latest fashion trends
 Woman - Make-up ideas & tips
Woman - Make-up ideas & tips
 Woman - Pregnancy & childbirth
Woman - Pregnancy & childbirth
 Woman - Relationship tips & advice
Woman - Relationship tips & advice
 Woman - Skin care tips
Woman - Skin care tips
 Woman - Weight loss & healty recipes
Woman - Weight loss & healty recipes
 Women - Breast cancer
Women - Breast cancer
 Women - Most luxurious jewelry brands & news
Women - Most luxurious jewelry brands & news
 Women - Beauty salon & spa
Women - Beauty salon & spa
 Women - Sexy & luxury lingerie
Women - Sexy & luxury lingerie
 World News
World News
 Youth & Parenting
Youth & Parenting
✗ Close categories
✗ Close categories
✗ Close categories
 Alexandr Dolgopolov
Alexandr Dolgopolov
 American Football
American Football
 Andy Murray
Andy Murray
 Athletics
Athletics
 Badmington
Badmington
 Baseball
Baseball
 Baseball - Arizona Diamondbacks
Baseball - Arizona Diamondbacks
 Baseball - Atlanta Braves
Baseball - Atlanta Braves
 Baseball - Baltimore Orioles
Baseball - Baltimore Orioles
 Baseball - Boston Red Sox
Baseball - Boston Red Sox
 Baseball - Chicago Cubs
Baseball - Chicago Cubs
 Baseball - Chicago White Sox
Baseball - Chicago White Sox
 Baseball - Cincinnati Reds
Baseball - Cincinnati Reds
 Baseball - Cleveland Indians
Baseball - Cleveland Indians
 Baseball - Colorado Rockies
Baseball - Colorado Rockies
 Baseball - Detroit Tigers
Baseball - Detroit Tigers
 Baseball - Houston Astros
Baseball - Houston Astros
 Baseball - Kansas City Royals
Baseball - Kansas City Royals
 Baseball - Los Angeles Angels of Anaheim
Baseball - Los Angeles Angels of Anaheim
 Baseball - Los Angeles Dodgers
Baseball - Los Angeles Dodgers
 Baseball - Miami Marlins
Baseball - Miami Marlins
 Baseball - Milwaukee Brewers
Baseball - Milwaukee Brewers
 Baseball - Minnesota Twins
Baseball - Minnesota Twins
 Baseball - New York Mets
Baseball - New York Mets
 Baseball - New York Yankees
Baseball - New York Yankees
 Baseball - Oakland Athletics
Baseball - Oakland Athletics
 Baseball - Philadelphia Phillies
Baseball - Philadelphia Phillies
 Baseball - Pittsburgh Pirates
Baseball - Pittsburgh Pirates
 Baseball - San Diego Padres
Baseball - San Diego Padres
 Baseball - San Francisco Giants
Baseball - San Francisco Giants
 Baseball - Seattle Mariners
Baseball - Seattle Mariners
 Baseball - St. Louis Cardinals
Baseball - St. Louis Cardinals
 Baseball - Tampa Bay Rays
Baseball - Tampa Bay Rays
 Baseball - Texas Rangers
Baseball - Texas Rangers
 Baseball - Toronto Blue Jays
Baseball - Toronto Blue Jays
 Baseball - Washington Nationals
Baseball - Washington Nationals
 Basketball
Basketball
 Basketball - Atlanta Hawks
Basketball - Atlanta Hawks
 Basketball - Boston Celtics
Basketball - Boston Celtics
 Basketball - Brooklyn Nets
Basketball - Brooklyn Nets
 Basketball - Charlotte Hornets
Basketball - Charlotte Hornets
 Basketball - Chicago Bulls
Basketball - Chicago Bulls
 Basketball - Cleveland Cavaliers
Basketball - Cleveland Cavaliers
 Basketball - Dallas Mavericks
Basketball - Dallas Mavericks
 Basketball - Denver Nuggets
Basketball - Denver Nuggets
 Basketball - Detroit Pistons
Basketball - Detroit Pistons
 Basketball - Golden State Warriors
Basketball - Golden State Warriors
 Basketball - Houston Rockets
Basketball - Houston Rockets
 Basketball - Indiana Pacers
Basketball - Indiana Pacers
 Basketball - Los Angeles Clippers
Basketball - Los Angeles Clippers
 Basketball - Los Angeles Lakers
Basketball - Los Angeles Lakers
 Basketball - Memphis Grizzlies
Basketball - Memphis Grizzlies
 Basketball - Miami Heat
Basketball - Miami Heat
 Basketball - Milwaukee Bucks
Basketball - Milwaukee Bucks
 Basketball - Minnesota Timberwolves
Basketball - Minnesota Timberwolves
 Basketball - New Orleans Pelicans
Basketball - New Orleans Pelicans
 Basketball - New York Knicks
Basketball - New York Knicks
 Basketball - Oklahoma City Thunder
Basketball - Oklahoma City Thunder
 Basketball - Orlando Magic
Basketball - Orlando Magic
 Basketball - Philadelphia 76ers
Basketball - Philadelphia 76ers
 Basketball - Phoenix Suns
Basketball - Phoenix Suns
 Basketball - Portland Trail Blazers
Basketball - Portland Trail Blazers
 Basketball - Sacramento Kings
Basketball - Sacramento Kings
 Basketball - San Antonio Spurs
Basketball - San Antonio Spurs
 Basketball - Toronto Raptors
Basketball - Toronto Raptors
 Basketball - Utah Jazz
Basketball - Utah Jazz
 Basketball - Washington Wizards
Basketball - Washington Wizards
 Body building
Body building
 Boxing
Boxing
 Cheerleading
Cheerleading
 Cricket
Cricket
 Cycling
Cycling
 Dancing
Dancing
 David Ferrer
David Ferrer
 David Goffin
David Goffin
 Downhill Skiing
Downhill Skiing
 Ernests Gulbis
Ernests Gulbis
 Fabio Fognini
Fabio Fognini
 Feliciano Lopez
Feliciano Lopez
 Figure Skating
Figure Skating
 Football - Arizona Cardinals
Football - Arizona Cardinals
 Football - Atlanta Falcons
Football - Atlanta Falcons
 Football - Baltimore Ravens
Football - Baltimore Ravens
 Football - Buffalo Bills
Football - Buffalo Bills
 Football - Carolina Panthers
Football - Carolina Panthers
 Football - Chicago Bears
Football - Chicago Bears
 Football - Cincinnati Bengals
Football - Cincinnati Bengals
 Football - Cleveland Browns
Football - Cleveland Browns
 Football - Dallas Cowboys
Football - Dallas Cowboys
 Football - Denver Broncos
Football - Denver Broncos
 Football - Detroit Lions
Football - Detroit Lions
 Football - Green Bay Packers
Football - Green Bay Packers
 Football - Houston Texans
Football - Houston Texans
 Football - Indianapolis Colts
Football - Indianapolis Colts
 Football - Jacksonville Jaguars
Football - Jacksonville Jaguars
 Football - Kansas City Chiefs
Football - Kansas City Chiefs
 Football - Miami Dolphins
Football - Miami Dolphins
 Football - Minnesota Vikings
Football - Minnesota Vikings
 Football - New England Patriots
Football - New England Patriots
 Football - New Orleans Saints
Football - New Orleans Saints
 Football - New York Giants
Football - New York Giants
 Football - New York Jets
Football - New York Jets
 Football - Oakland Raiders
Football - Oakland Raiders
 Football - Philadelphia Eagles
Football - Philadelphia Eagles
 Football - Pittsburgh Steelers
Football - Pittsburgh Steelers
 Football - San Diego Chargers
Football - San Diego Chargers
 Football - San Francisco 49ers
Football - San Francisco 49ers
 Football - Seattle Seahawks
Football - Seattle Seahawks
 Football - St. Louis Rams
Football - St. Louis Rams
 Football - Tampa Bay Buccaneers
Football - Tampa Bay Buccaneers
 Football - Tennessee Titans
Football - Tennessee Titans
 Football - Washington Redskins
Football - Washington Redskins
 Formula 1
Formula 1
 Formula 1 - Force India Videos
Formula 1 - Force India Videos
 Formula 1 - Infiniti Red Bull Racing Videos
Formula 1 - Infiniti Red Bull Racing Videos
 Formula 1 - Live Stream & News
Formula 1 - Live Stream & News
 Formula 1 - McLaren Videos
Formula 1 - McLaren Videos
 Formula 1 - Mercedes AMG Petronas Videos
Formula 1 - Mercedes AMG Petronas Videos
 Formula 1 - Sauber F1 Team Videos
Formula 1 - Sauber F1 Team Videos
 Formula 1 - Scuderia Ferrari Videos
Formula 1 - Scuderia Ferrari Videos
 Formula 1 - Scuderia Toro Rosso Videos
Formula 1 - Scuderia Toro Rosso Videos
 Formula 1 - Team Lotus Videos
Formula 1 - Team Lotus Videos
 Formula 1 - Williams Martini videos
Formula 1 - Williams Martini videos
 Gael Monfils
Gael Monfils
 Gilles Simon
Gilles Simon
 Golf
Golf
 Grigor Dimitrov
Grigor Dimitrov
 Gymnastics
Gymnastics
 Horse Racing
Horse Racing
 Ice Hockey
Ice Hockey
 Ice Hockey - Anaheim Ducks
Ice Hockey - Anaheim Ducks
 Ice Hockey - Arizona Coyotes
Ice Hockey - Arizona Coyotes
 Ice Hockey - Boston Bruins
Ice Hockey - Boston Bruins
 Ice Hockey - Buffalo Sabres
Ice Hockey - Buffalo Sabres
 Ice Hockey - Calgary Flames
Ice Hockey - Calgary Flames
 Ice Hockey - Carolina Hurricanes
Ice Hockey - Carolina Hurricanes
 Ice Hockey - Chicago Blackhawks
Ice Hockey - Chicago Blackhawks
 Ice Hockey - Colorado Avalanche
Ice Hockey - Colorado Avalanche
 Ice Hockey - Columbus Blue Jackets
Ice Hockey - Columbus Blue Jackets
 Ice Hockey - Dallas Stars
Ice Hockey - Dallas Stars
 Ice Hockey - Detroit Red Wings
Ice Hockey - Detroit Red Wings
 Ice Hockey - Edmonton Oilers
Ice Hockey - Edmonton Oilers
 Ice Hockey - Florida Panthers
Ice Hockey - Florida Panthers
 Ice Hockey - Los Angeles Kings
Ice Hockey - Los Angeles Kings
 Ice Hockey - Minnesota Wild
Ice Hockey - Minnesota Wild
 Ice Hockey - Montreal Canadiens
Ice Hockey - Montreal Canadiens
 Ice Hockey - Nashville Predators
Ice Hockey - Nashville Predators
 Ice Hockey - New Jersey Devils
Ice Hockey - New Jersey Devils
 Ice Hockey - New York Islanders
Ice Hockey - New York Islanders
 Ice Hockey - New York Rangers
Ice Hockey - New York Rangers
 Ice Hockey - Ottawa Senators
Ice Hockey - Ottawa Senators
 Ice Hockey - Philadelphia Flyers
Ice Hockey - Philadelphia Flyers
 Ice Hockey - Pittsburg Penguins
Ice Hockey - Pittsburg Penguins
 Ice Hockey - San Jose Sharks
Ice Hockey - San Jose Sharks
 Ice Hockey - St. Louis Blues
Ice Hockey - St. Louis Blues
 Ice Hockey - Tampa Bay Lightning
Ice Hockey - Tampa Bay Lightning
 Ice Hockey - Toronto Maple Leafs
Ice Hockey - Toronto Maple Leafs
 Ice Hockey - Vancouver Canucks
Ice Hockey - Vancouver Canucks
 Ice Hockey - Washington Capitals
Ice Hockey - Washington Capitals
 Ice Hockey - Winnipeg Jets
Ice Hockey - Winnipeg Jets
 Ivo Karlovic
Ivo Karlovic
 Jeremy Chardy
Jeremy Chardy
 Jo-Wilfried Tsonga
Jo-Wilfried Tsonga
 John Isner
John Isner
 Julien Benneteau
Julien Benneteau
 Kei Nishikori
Kei Nishikori
 Kevin Anderson
Kevin Anderson
 Lacrosse
Lacrosse
 Leonardo Mayer
Leonardo Mayer
 Marin Cilic
Marin Cilic
 Milos Raonic
Milos Raonic
 MMA
MMA
 Nascar
Nascar
 NBA twitter top10
NBA twitter top10
 NFL
NFL
 Novak Djokovic
Novak Djokovic
 Pablo Cuevas
Pablo Cuevas
 Philipp Kohlschreiber
Philipp Kohlschreiber
 Rafael Nadal
Rafael Nadal
 Richard Gasquet
Richard Gasquet
 Roberto Bautista Agut
Roberto Bautista Agut
 Roger Federer
Roger Federer
 Skateboarding
Skateboarding
 Skiing
Skiing
 Soccer - Atlanta United FC
Soccer - Atlanta United FC
 Soccer - Chicago Fire
Soccer - Chicago Fire
 Soccer - Colorado Rapids
Soccer - Colorado Rapids
 Soccer - Columbus Crew
Soccer - Columbus Crew
 Soccer - D.C. United
Soccer - D.C. United
 Soccer - FC Dallas
Soccer - FC Dallas
 Soccer - Houston Dynamo
Soccer - Houston Dynamo
 Soccer - LA Galaxy
Soccer - LA Galaxy
 Soccer - Los Angeles Football Club
Soccer - Los Angeles Football Club
 Soccer - Major League
Soccer - Major League
 Soccer - Montreal Impact
Soccer - Montreal Impact
 Soccer - New England Revolution
Soccer - New England Revolution
 Soccer - New York City FC
Soccer - New York City FC
 Soccer - New York Red Bulls
Soccer - New York Red Bulls
 Soccer - Orlando City SC
Soccer - Orlando City SC
 Soccer - Philadelphia Union
Soccer - Philadelphia Union
 Soccer - Portland Timbers
Soccer - Portland Timbers
 Soccer - Real Salt Lake
Soccer - Real Salt Lake
 Soccer - San Jose Earthquakes
Soccer - San Jose Earthquakes
 Soccer - Seattle Sounders FC
Soccer - Seattle Sounders FC
 Soccer - Sporting Kansas City
Soccer - Sporting Kansas City
 Soccer - Toronto FC
Soccer - Toronto FC
 Soccer - United States Soccer Federation
Soccer - United States Soccer Federation
 Soccer - Vancouver Whitecaps FC
Soccer - Vancouver Whitecaps FC
 Stanislas Wawrinka
Stanislas Wawrinka
 Swimming
Swimming
 Tennis
Tennis
 Tomas Berdych
Tomas Berdych
 Tommy Robredo
Tommy Robredo
 Top 30 tennis players
Top 30 tennis players
 Volleyball
Volleyball
 World Cup soccer
World Cup soccer
 World Soccer
World Soccer
 Wrestling
Wrestling
✗ Close categories
✗ Close categories
✗ Close categories
 Akron
Akron
 Alabama
Alabama
 Alaska
Alaska
 Albuquerque
Albuquerque
 Anaheim
Anaheim
 Anchorage
Anchorage
 Arizona
Arizona
 Arkansas
Arkansas
 Arlington
Arlington
 Atlanta
Atlanta
 Aurora
Aurora
 Austin
Austin
 Bakersfield
Bakersfield
 Baltimore
Baltimore
 Baton Rouge
Baton Rouge
 Birmingham
Birmingham
 Boston
Boston
 Buffalo
Buffalo
 California
California
 Chandler
Chandler
 Charlotte
Charlotte
 Chesapeake
Chesapeake
 Chicago
Chicago
 Chula Vista
Chula Vista
 Cincinnati
Cincinnati
 Cleveland
Cleveland
 Colorado
Colorado
 Colorado Springs
Colorado Springs
 Columbus
Columbus
 Connecticut
Connecticut
 Corpus Christi
Corpus Christi
 Dallas
Dallas
 Delaware
Delaware
 Denver
Denver
 Detroit
Detroit
 Durham
Durham
 El Paso
El Paso
 Florida
Florida
 Fort Wayne
Fort Wayne
 Fort Worth
Fort Worth
 Fremont
Fremont
 Fresno
Fresno
 Garland
Garland
 Georgia
Georgia
 Glendale
Glendale
 Greensboro
Greensboro
 Hawaii
Hawaii
 Henderson
Henderson
 Hialeah
Hialeah
 Hollywood
Hollywood
 Honolulu
Honolulu
 Houston
Houston
 Idaho
Idaho
 Illinois
Illinois
 Indiana
Indiana
 Indianapolis
Indianapolis
 Iowa
Iowa
 Jacksonville
Jacksonville
 Jersey City
Jersey City
 Kansas
Kansas
 Kansas City
Kansas City
 Kentucky
Kentucky
 Laredo
Laredo
 Las Vegas
Las Vegas
 Lexington
Lexington
 Lincoln
Lincoln
 Long Beach
Long Beach
 Los Angeles
Los Angeles
 Louisiana
Louisiana
 Louisville
Louisville
 Lubbock
Lubbock
 Madison
Madison
 Maine
Maine
 Maryland
Maryland
 Massachusetts
Massachusetts
 Memphis
Memphis
 Mesa
Mesa
 Miami
Miami
 Michigan
Michigan
 Milwaukee
Milwaukee
 Minneapolis
Minneapolis
 Minnesota
Minnesota
 Mississippi
Mississippi
 Missouri
Missouri
 Modesto
Modesto
 Montana
Montana
 Montgomery
Montgomery
 Nashville
Nashville
 Nebraska
Nebraska
 Nevada
Nevada
 New Hampshire
New Hampshire
 New Jersey
New Jersey
 New Mexico
New Mexico
 New Orleans
New Orleans
 New York
New York
 Newark
Newark
 Norfolk
Norfolk
 North Carolina
North Carolina
 North Dakota
North Dakota
 NY Bronx
NY Bronx
 NY Brooklyn
NY Brooklyn
 NY Chinatown
NY Chinatown
 NY Manhattan
NY Manhattan
 NY Queens
NY Queens
 NY Staten Island
NY Staten Island
 Oakland
Oakland
 Ohio
Ohio
 Oklahoma
Oklahoma
 Oklahoma City
Oklahoma City
 Omaha
Omaha
 Oregon
Oregon
 Orlando
Orlando
 Pennsylvania
Pennsylvania
 Philadelphia
Philadelphia
 Phoenix
Phoenix
 Pittsburgh
Pittsburgh
 Plano
Plano
 Portland
Portland
 Raleigh
Raleigh
 Reno
Reno
 Rhode Island
Rhode Island
 Riverside
Riverside
 Rochester
Rochester
 Sacramento
Sacramento
 Saint Louis
Saint Louis
 Saint Paul
Saint Paul
 Saint Petersburg
Saint Petersburg
 San Antonio
San Antonio
 San Diego
San Diego
 San Francisco
San Francisco
 San Jose
San Jose
 Santa Ana
Santa Ana
 Scottsdale
Scottsdale
 Seattle
Seattle
 Shreveport
Shreveport
 South Carolina
South Carolina
 South Dakota
South Dakota
 Stockton
Stockton
 Tampa
Tampa
 Tennessee
Tennessee
 Texas
Texas
 Toledo
Toledo
 Tulsa
Tulsa
 Tuscon
Tuscon
 Utah
Utah
 Vermont
Vermont
 Virginia
Virginia
 Virginia Beach
Virginia Beach
 Washington
Washington
 West Virginia
West Virginia
 Wichita
Wichita
 Wisconsin
Wisconsin
 Wyoming
Wyoming
✗ Close categories
✗ Close categories
✗ Close categories
 Alternative rock
Alternative rock
 Blues
Blues
 Classic Rock & Pop
Classic Rock & Pop
 Country news
Country news
 Country videos
Country videos
 Dance news
Dance news
 Dance videos
Dance videos
 Dubstep news & videos
Dubstep news & videos
 EDM
EDM
 Heavy Metal
Heavy Metal
 Hip-Hop news
Hip-Hop news
 Hip-Hop videos
Hip-Hop videos
 Jazz
Jazz
 Latin
Latin
 Minimal Techno
Minimal Techno
 New EDM, Trance, Hip hop and R&B Music
New EDM, Trance, Hip hop and R&B Music
 Pop videos
Pop videos
 R&B Hip-Hop news
R&B Hip-Hop news
 R&B Hip-Hop videos
R&B Hip-Hop videos
 R&B News
R&B News
 R&B videos
R&B videos
 Reggae
Reggae
 Retro Trance & Dance Music
Retro Trance & Dance Music
 Rock
Rock
 Soul
Soul
 Soundrange Dub Rebel
Soundrange Dub Rebel
 Spinnin' Records
Spinnin' Records
 Techno News & mixes
Techno News & mixes
 Trance Music
Trance Music
 Trance news
Trance news
 Urban & Caribbean
Urban & Caribbean
✗ Close categories
✗ Close categories
✗ Close categories
 Aaron Rodgers
Aaron Rodgers
 Adam Sandler
Adam Sandler
 Adele
Adele
 Al Pacino
Al Pacino
 Amanda Seyfried
Amanda Seyfried
 Amy Adams
Amy Adams
 Angelina Jolie
Angelina Jolie
 Ashley Judd
Ashley Judd
 Ashton Kutcher
Ashton Kutcher
 Barack Obama
Barack Obama
 Ben Affleck
Ben Affleck
 Beyoncé
Beyoncé
 Big Sean
Big Sean
 Bill Gates
Bill Gates
 Bill Murray
Bill Murray
 Billie Eilish
Billie Eilish
 Bon Jovi
Bon Jovi
 Brad Pitt
Brad Pitt
 Bradley Cooper
Bradley Cooper
 Brendan Jordan
Brendan Jordan
 Britney Spears
Britney Spears
 Bruce Springsteen
Bruce Springsteen
 Bruce Willis
Bruce Willis
 Bruno Mars
Bruno Mars
 Bryan Cranston
Bryan Cranston
 Busta Rhymes
Busta Rhymes
 Cameron Diaz
Cameron Diaz
 Catherine Zeta-Jones
Catherine Zeta-Jones
 Channing Tatum
Channing Tatum
 Charlie Sheen
Charlie Sheen
 Chris Hemsworth
Chris Hemsworth
 Christina Aguilera
Christina Aguilera
 Christoph Waltz
Christoph Waltz
 Danny Trejo
Danny Trejo
 David Beckham
David Beckham
 David Hasselhoff
David Hasselhoff
 David Letterman
David Letterman
 Denzel Washington
Denzel Washington
 Derek Jeter
Derek Jeter
 DJ 3lau
DJ 3lau
 DJ Above & Beyond
DJ Above & Beyond
 DJ Afrojack
DJ Afrojack
 DJ Alesso
DJ Alesso
 DJ Aly & Fila
DJ Aly & Fila
 DJ Andrew Rayel
DJ Andrew Rayel
 DJ Angerfist
DJ Angerfist
 DJ Armin Van Buuren
DJ Armin Van Buuren
 DJ Arty
DJ Arty
 DJ ATB
DJ ATB
 DJ Audien
DJ Audien
 DJ Avicii
DJ Avicii
 DJ Axwell
DJ Axwell
 DJ Bingo Players
DJ Bingo Players
 DJ Bl3ND
DJ Bl3ND
 DJ Blasterjaxx
DJ Blasterjaxx
 DJ Borgeous
DJ Borgeous
 DJ Borgore
DJ Borgore
 DJ Boy George
DJ Boy George
 DJ Brennan Heart
DJ Brennan Heart
 DJ Calvin Harris
DJ Calvin Harris
 DJ Carl Cox
DJ Carl Cox
 DJ Carnage
DJ Carnage
 DJ Code Black
DJ Code Black
 DJ Coone
DJ Coone
 DJ Cosmic Gate
DJ Cosmic Gate
 DJ Da Tweekaz
DJ Da Tweekaz
 DJ Dada Life
DJ Dada Life
 DJ Daft Punk
DJ Daft Punk
 DJ Dannic
DJ Dannic
 DJ Dash Berlin
DJ Dash Berlin
 DJ David Guetta
DJ David Guetta
 DJ Deadmau5
DJ Deadmau5
 DJ Deorro
DJ Deorro
 DJ Diego Miranda
DJ Diego Miranda
 DJ Dillon Francis
DJ Dillon Francis
 DJ Dimitri Vegas & Like Mike
DJ Dimitri Vegas & Like Mike
 DJ Diplo
DJ Diplo
 DJ Don Diablo
DJ Don Diablo
 DJ DVBBS
DJ DVBBS
 DJ Dyro
DJ Dyro
 DJ Eric Prydz
DJ Eric Prydz
 Dj Fabian (DJ Fabvd M)
Dj Fabian (DJ Fabvd M)
 DJ Fedde Le Grand
DJ Fedde Le Grand
 DJ Felguk
DJ Felguk
 DJ Ferry Corsten
DJ Ferry Corsten
 DJ Firebeatz
DJ Firebeatz
 DJ Frontliner
DJ Frontliner
 DJ Gabry Ponte
DJ Gabry Ponte
 DJ Gareth Emery
DJ Gareth Emery
 DJ Hardwell
DJ Hardwell
 DJ Headhunterz
DJ Headhunterz
 DJ Heatbeat
DJ Heatbeat
 DJ Infected Mushroom
DJ Infected Mushroom
 DJ John O'Callaghan
DJ John O'Callaghan
 DJ Kaskade
DJ Kaskade
 DJ Knife Party
DJ Knife Party
 DJ Krewella
DJ Krewella
 DJ Kura
DJ Kura
 DJ Laidback Luke
DJ Laidback Luke
 DJ Madeon
DJ Madeon
 DJ MAKJ
DJ MAKJ
 DJ Markus Schulz
DJ Markus Schulz
 DJ Martin Garrix
DJ Martin Garrix
 DJ Merk & Kremont
DJ Merk & Kremont
 DJ Mike Candys
DJ Mike Candys
 DJ Nervo
DJ Nervo
 DJ Nicky Romero
DJ Nicky Romero
 DJ Noisecontrollers
DJ Noisecontrollers
 DJ Oliver Heldens
DJ Oliver Heldens
 DJ Orjan Nilsen
DJ Orjan Nilsen
 DJ Paul Van Dyk
DJ Paul Van Dyk
 DJ Porter Robinson
DJ Porter Robinson
 DJ Quentin Mosimann
DJ Quentin Mosimann
 DJ Quintino
DJ Quintino
 DJ R3hab
DJ R3hab
 DJ Radical Redemption
DJ Radical Redemption
 DJ Richie Hawtin
DJ Richie Hawtin
 DJ Sander Van Doorn
DJ Sander Van Doorn
 DJ Sebastian Ingrosso
DJ Sebastian Ingrosso
 DJ Showtek
DJ Showtek
 DJ Skrillex
DJ Skrillex
 DJ Snake
DJ Snake
 DJ Steve Angello
DJ Steve Angello
 DJ Steve Aoki
DJ Steve Aoki
 DJ Tenishia
DJ Tenishia
 DJ The Chainsmokers
DJ The Chainsmokers
 DJ Tiddey
DJ Tiddey
 DJ Tiesto
DJ Tiesto
 DJ TJR
DJ TJR
 DJ Umek
DJ Umek
 DJ Ummet Ozcan
DJ Ummet Ozcan
 DJ Vicetone
DJ Vicetone
 DJ VINAI
DJ VINAI
 DJ W&W
DJ W&W
 DJ Wildstylez
DJ Wildstylez
 DJ Wolfpack
DJ Wolfpack
 DJ Yves V
DJ Yves V
 DJ Zatox
DJ Zatox
 DJ Zedd
DJ Zedd
 DJ Zomboy
DJ Zomboy
 DMX
DMX
 Donald Trump
Donald Trump
 Dr. Dre
Dr. Dre
 Dr. Phil McGraw
Dr. Phil McGraw
 Drew Brees
Drew Brees
 Dwayne Johnson
Dwayne Johnson
 Dwyane Wade
Dwyane Wade
 Eddie Murphy
Eddie Murphy
 Edward Snowden
Edward Snowden
 Ellen DeGeneres
Ellen DeGeneres
 Emily Mortimer
Emily Mortimer
 Eminem
Eminem
 Emma Thompson
Emma Thompson
 Famke Janssen
Famke Janssen
 Farrah Fawcett
Farrah Fawcett
 Floyd Mayweather
Floyd Mayweather
 Floyd Mayweather- Boxing
Floyd Mayweather- Boxing
 Franco Nero
Franco Nero
 Gabby Douglas
Gabby Douglas
 Gabriel Macht
Gabriel Macht
 Garth Brooks
Garth Brooks
 Gemma Arterton
Gemma Arterton
 George Clooney
George Clooney
 George Pal
George Pal
 Gisele Bundchen
Gisele Bundchen
 Glenn Beck
Glenn Beck
 Golshifteh Farahani
Golshifteh Farahani
 Greg Giraldo
Greg Giraldo
 Gwyneth Paltrow
Gwyneth Paltrow
 Howard Stern
Howard Stern
 Hulk Hogan
Hulk Hogan
 Ice Cube
Ice Cube
 J.J. Abrams
J.J. Abrams
 Jack Nicholson
Jack Nicholson
 James Caviezel
James Caviezel
 James Patterson
James Patterson
 Jane Fonda
Jane Fonda
 Jason Aldean
Jason Aldean
 Jason Bateman
Jason Bateman
 Jason London
Jason London
 Jason Schwartzman
Jason Schwartzman
 Jason Statham
Jason Statham
 Jay Leno
Jay Leno
 Jay-Z
Jay-Z
 Jeananne Goossen
Jeananne Goossen
 Jennifer Aniston
Jennifer Aniston
 Jennifer Garner
Jennifer Garner
 Jennifer Lawrence
Jennifer Lawrence
 Jennifer Lopez
Jennifer Lopez
 Jeremy Renner
Jeremy Renner
 Jerry Seinfeld
Jerry Seinfeld
 Jessica Alba
Jessica Alba
 Jessica Chastain
Jessica Chastain
 Jim Carrey
Jim Carrey
 Jim Parsons
Jim Parsons
 Jimmy Buffett
Jimmy Buffett
 Jimmy Fallon
Jimmy Fallon
 Joel Zimmerman
Joel Zimmerman
 John Green
John Green
 John Malkovich
John Malkovich
 Johnny Depp
Johnny Depp
 Jon Hamm
Jon Hamm
 Jon Lester
Jon Lester
 Jon Stewart
Jon Stewart
 Joss Whedon
Joss Whedon
 Jude Law
Jude Law
 Judy Sheindlin
Judy Sheindlin
 Julia Roberts
Julia Roberts
 Justin Bieber
Justin Bieber
 Justin Timberlake
Justin Timberlake
 Kaley Cuoco
Kaley Cuoco
 Kanye West
Kanye West
 Kate Upton
Kate Upton
 Kathleen Turner
Kathleen Turner
 Katy Perry
Katy Perry
 Kelly Lynch
Kelly Lynch
 Kenny Chesney
Kenny Chesney
 Kerry Washington
Kerry Washington
 Kevin Durant
Kevin Durant
 Kevin Hart
Kevin Hart
 Kevin Spacey
Kevin Spacey
 Kim Kardashian
Kim Kardashian
 Kobe Bryant
Kobe Bryant
 Kristen Stewart
Kristen Stewart
 Lady Gaga
Lady Gaga
 LeBron James
LeBron James
 Leonardo DiCaprio
Leonardo DiCaprio
 Lil Wayne
Lil Wayne
 Lindsay Lohan
Lindsay Lohan
 Lucas Black
Lucas Black
 Luke Bryan
Luke Bryan
 Madonna
Madonna
 Mahendra Singh Dhoni
Mahendra Singh Dhoni
 Maksim Vitorgan
Maksim Vitorgan
 Manny Pacquiao
Manny Pacquiao
 Maria Sharapova
Maria Sharapova
 Marisa Tomei
Marisa Tomei
 Mark Harmon
Mark Harmon
 Mark Wahlberg
Mark Wahlberg
 Mark Zuckerberg
Mark Zuckerberg
 Martin Sheen
Martin Sheen
 Mary-Louise Parker
Mary-Louise Parker
 Matt Damon
Matt Damon
 Matthew McConaughey
Matthew McConaughey
 Megan Fox
Megan Fox
 Meryl Streep
Meryl Streep
 Method Man
Method Man
 Michael Bay
Michael Bay
 Michael Jordan
Michael Jordan
 Michael Phelps
Michael Phelps
 Mickey Rourke
Mickey Rourke
 Mike Tyson & Boxing
Mike Tyson & Boxing
 Miley Cyrus
Miley Cyrus
 Morgan Freeman
Morgan Freeman
 Mos Def
Mos Def
 Naomi Watts
Naomi Watts
 Natalie Portman
Natalie Portman
 Natalya Rudakova
Natalya Rudakova
 Neil Patrick Harris
Neil Patrick Harris
 Nicolas Cage
Nicolas Cage
 Nicole Kidman
Nicole Kidman
 Novak Djokovic
Novak Djokovic
 One Direction- Band
One Direction- Band
 Oprah Winfrey
Oprah Winfrey
 P!nk
P!nk
 Paige Simpson
Paige Simpson
 Pamela Anderson
Pamela Anderson
 Patricia Arquette
Patricia Arquette
 Patrick Wilson
Patrick Wilson
 Paul Rudd
Paul Rudd
 Peter Billingsley
Peter Billingsley
 Peyton Manning
Peyton Manning
 Pharrell Williams
Pharrell Williams
 Phil Mickelson
Phil Mickelson
 Philip Seymour Hoffman
Philip Seymour Hoffman
 Rafael Nadal
Rafael Nadal
 Rihanna
Rihanna
 Robert De Niro
Robert De Niro
 Robert Downey Jr
Robert Downey Jr
 Robert Pattinson
Robert Pattinson
 Robert Redford
Robert Redford
 Roger Federer
Roger Federer
 Roman Coppola
Roman Coppola
 Ron Howard
Ron Howard
 Ron Jeremy
Ron Jeremy
 Rush Limbaugh
Rush Limbaugh
 Ryan Seacrest
Ryan Seacrest
 Sandra Bullock
Sandra Bullock
 Sarah Jessica Parker
Sarah Jessica Parker
 Sarah Shahi
Sarah Shahi
 Scarlett Johansson
Scarlett Johansson
 Sean "Diddy" Combs
Sean "Diddy" Combs
 Sean Hannity
Sean Hannity
 Sean Penn
Sean Penn
 Selena Gomez
Selena Gomez
 Serena Williams
Serena Williams
 Seth MacFarlane
Seth MacFarlane
 Seth Rogen
Seth Rogen
 Shakira
Shakira
 Shia LaBeouf
Shia LaBeouf
 Skylar Astin
Skylar Astin
 Snoop Dogg
Snoop Dogg
 Sofia Vergara
Sofia Vergara
 Stacey Dash
Stacey Dash
 Stephen King
Stephen King
 Steven Spielberg
Steven Spielberg
 Sylvester Stallone
Sylvester Stallone
 Taylor Swift
Taylor Swift
 The Eagles- Band
The Eagles- Band
 Tiger Woods
Tiger Woods
 Tim Tebow
Tim Tebow
 Toby Keith
Toby Keith
 Tom Cruise
Tom Cruise
 Tom Hanks
Tom Hanks
 Tom Hardy
Tom Hardy
 Tommy Lee Jones
Tommy Lee Jones
 Tyler Perry
Tyler Perry
 Usain Bolt
Usain Bolt
 Veronica Roth
Veronica Roth
 Vin Diesel
Vin Diesel
 Vince Vaughn
Vince Vaughn
 Vincent D'Onofrio
Vincent D'Onofrio
 Viola Davis
Viola Davis
 Warren Buffet
Warren Buffet
 Wesley Snipes
Wesley Snipes
 Will Ferrell
Will Ferrell
 Will Smith
Will Smith
 William Shatner
William Shatner
 Zooey Deschanel
Zooey Deschanel
✗ Close categories
✗ Close categories
✗ Close categories
 Accountancy
Accountancy
 Administration
Administration
 Advertising
Advertising
 Aerospace
Aerospace
 Agriculture
Agriculture
 Analyst
Analyst
 Animals
Animals
 Antique
Antique
 Archaeology
Archaeology
 Architecture
Architecture
 Arts
Arts
 Astrology
Astrology
 Astronomy
Astronomy
 Automotive
Automotive
 Aviation
Aviation
 Bakery
Bakery
 Biotechnology
Biotechnology
 Cabaret
Cabaret
 Call center
Call center
 Car News
Car News
 Care
Care
 Catering
Catering
 Charities
Charities
 Chemistry
Chemistry
 Child care
Child care
 Cinema, Theater & TV
Cinema, Theater & TV
 Cleaning industry
Cleaning industry
 Coaching
Coaching
 Construction
Construction
 Customs
Customs
 Dairy industry
Dairy industry
 Dance & ballet
Dance & ballet
 Debt collection agencies
Debt collection agencies
 Defense
Defense
 Dj
Dj
 Economy
Economy
 Education & Training
Education & Training
 Entrepreneur
Entrepreneur
 Financial
Financial
 Firefighter
Firefighter
 Fisheries
Fisheries
 Flowers
Flowers
 FMCG
FMCG
 Food
Food
 Fruit & Vegetables
Fruit & Vegetables
 Gardener
Gardener
 Genealogy
Genealogy
 General News
General News
 Government
Government
 Hair stylist
Hair stylist
 Hotel
Hotel
 HR & Recruitment
HR & Recruitment
 ICT
ICT
 Insurance
Insurance
 IT Executive
IT Executive
 Jobs
Jobs
 Justice
Justice
 Lawyer
Lawyer
 Legal
Legal
 Library
Library
 Logistics
Logistics
 Marketing
Marketing
 Meat industry
Meat industry
 Medical Industry
Medical Industry
 Mining
Mining
 Nurse
Nurse
 Online Trends
Online Trends
 Painter
Painter
 Pharmaceutical
Pharmaceutical
 Pharmacy
Pharmacy
 Photography
Photography
 Physical therapy
Physical therapy
 Police
Police
 Political
Political
 PR Public relations
PR Public relations
 Production & Industry
Production & Industry
 Project Management
Project Management
 Psychology
Psychology
 Public Transport
Public Transport
 Publisher
Publisher
 Real estate
Real estate
 Rehab
Rehab
 Research & Development
Research & Development
 Restaurant
Restaurant
 Retail
Retail
 Sales
Sales
 Security
Security
 SEO
SEO
 Shipping
Shipping
 Social work
Social work
 Sustainable Energy
Sustainable Energy
 Teacher
Teacher
 Telecom
Telecom
 Tourism
Tourism
 Traditional Energy
Traditional Energy
 Transport
Transport
 Travel Industry
Travel Industry
 Vacancies
Vacancies
 Vegetables
Vegetables
 Web Design
Web Design
✗ Close categories
✗ Close categories
✗ Close categories
 $ABBC ABBC Coin
$ABBC ABBC Coin
 $ABT Arcblock
$ABT Arcblock
 $ADA Cardano
$ADA Cardano
 $ADK Aidos Kuneen
$ADK Aidos Kuneen
 $AE Aeternity
$AE Aeternity
 $AGVC AgaveCoin
$AGVC AgaveCoin
 $AION Aion
$AION Aion
 $ALGO Algorand
$ALGO Algorand
 $ANT Aragon
$ANT Aragon
 $ARDR Ardor
$ARDR Ardor
 $ARK Ark
$ARK Ark
 $ATOM Cosmos
$ATOM Cosmos
 $BASE Base Protocol
$BASE Base Protocol
 $BAT Basic Attention Token
$BAT Basic Attention Token
 $BCD Bitcoin Diamond
$BCD Bitcoin Diamond
 $BCH Bitcoin Cash
$BCH Bitcoin Cash
 $BCN Bytecoin
$BCN Bytecoin
 $BCZERO Buggyra Coin Zero
$BCZERO Buggyra Coin Zero
 $BDX Beldex
$BDX Beldex
 $BEAM Beam
$BEAM Beam
 $BF BitForex Token
$BF BitForex Token
 $BHD BitcoinHD
$BHD BitcoinHD
 $BHP BHPCoin
$BHP BHPCoin
 $BIX Bibox Token
$BIX Bibox Token
 $BLOCK Blocknet
$BLOCK Blocknet
 $BNB Binance Coin
$BNB Binance Coin
 $BNK Bankera
$BNK Bankera
 $BNT Bancor
$BNT Bancor
 $BOA BOSAGORA
$BOA BOSAGORA
 $BONDLY Bondly
$BONDLY Bondly
 $BOTX botXcoin
$BOTX botXcoin
 $BRD Bread
$BRD Bread
 $BRZE Breezecoin
$BRZE Breezecoin
 $BST BlockStamp
$BST BlockStamp
 $BSV Bitcoin SV
$BSV Bitcoin SV
 $BTC Bitcoin
$BTC Bitcoin
 $BTC2 Bitcoin 2
$BTC2 Bitcoin 2
 $BTG Bitcoin Gold
$BTG Bitcoin Gold
 $BTM Bytom
$BTM Bytom
 $BTMX BitMax Token
$BTMX BitMax Token
 $BTS BitShares
$BTS BitShares
 $BTT BitTorrent
$BTT BitTorrent
 $BUSD Binance USD
$BUSD Binance USD
 $BXK Bitbook Gambling
$BXK Bitbook Gambling
 $CCA Counos Coin
$CCA Counos Coin
 $CENNZ Centrality
$CENNZ Centrality
 $CHSB SwissBorg
$CHSB SwissBorg
 $CHZ Chiliz
$CHZ Chiliz
 $CIX100 Cryptoindex.com 100
$CIX100 Cryptoindex.com 100
 $CKB Nervos Network
$CKB Nervos Network
 $CNX Cryptonex
$CNX Cryptonex
 $CRO Crypto.com Coin
$CRO Crypto.com Coin
 $CRPT Crypterium
$CRPT Crypterium
 $CSC CasinoCoin
$CSC CasinoCoin
 $CTXC Cortex
$CTXC Cortex
 $CVC Civic
$CVC Civic
 $DAG Constellation
$DAG Constellation
 $DAI Multi-collateral DAI
$DAI Multi-collateral DAI
 $DASH Dash
$DASH Dash
 $DCN Dentacoin
$DCN Dentacoin
 $DCR Decred
$DCR Decred
 $DDIM DuckDAO Dime
$DDIM DuckDAO Dime
 $DENT Dent
$DENT Dent
 $DGB DigiByte
$DGB DigiByte
 $DGD DigixDAO
$DGD DigixDAO
 $DGTX Digitex Futures
$DGTX Digitex Futures
 $DIVI Divi
$DIVI Divi
 $DMT DMarket
$DMT DMarket
 $DOGE Dogecoin
$DOGE Dogecoin
 $DPT Diamond Platform Token
$DPT Diamond Platform Token
 $DRG Dragon Coins
$DRG Dragon Coins
 $DTR Dynamic Trading Rights
$DTR Dynamic Trading Rights
 $DUCK Duck Liquidity Pool
$DUCK Duck Liquidity Pool
 $DX DxChain Token
$DX DxChain Token
 $ECOREAL Ecoreal Estate
$ECOREAL Ecoreal Estate
 $EDC EDC Blockchain
$EDC EDC Blockchain
 $EKT EDUCare
$EKT EDUCare
 $ELA Elastos
$ELA Elastos
 $ELF aelf
$ELF aelf
 $ENG Enigma
$ENG Enigma
 $ENJ Enjin Coin
$ENJ Enjin Coin
 $EON Dimension Chain
$EON Dimension Chain
 $EOS EOS
$EOS EOS
 $ERD Elrond
$ERD Elrond
 $ETC Ethereum Classic
$ETC Ethereum Classic
 $ETH Ethereum
$ETH Ethereum
 $ETN Electroneum
$ETN Electroneum
 $ETP Metaverse ETP
$ETP Metaverse ETP
 $EURS STASIS EURO
$EURS STASIS EURO
 $EVR Everus
$EVR Everus
 $FAB FABRK
$FAB FABRK
 $FCT Factom
$FCT Factom
 $FET Fetch.ai
$FET Fetch.ai
 $FLG Folgory Coin
$FLG Folgory Coin
 $FST 1irstcoin
$FST 1irstcoin
 $FTM Fantom
$FTM Fantom
 $FTT FTX Token
$FTT FTX Token
 $FUN FunFair
$FUN FunFair
 $FXC Flexacoin
$FXC Flexacoin
 $GAP GAPS
$GAP GAPS
 $GNO Gnosis
$GNO Gnosis
 $GNT Golem
$GNT Golem
 $GO GoChain
$GO GoChain
 $GRIN Grin
$GRIN Grin
 $GRS Groestlcoin
$GRS Groestlcoin
 $GT Gatechain Token
$GT Gatechain Token
 $GTN GlitzKoin
$GTN GlitzKoin
 $GXC GXChain
$GXC GXChain
 $HBAR Hedera Hashgraph
$HBAR Hedera Hashgraph
 $HC HyperCash
$HC HyperCash
 $HEDG HedgeTrade
$HEDG HedgeTrade
 $HOT Holo
$HOT Holo
 $HPT Huobi Pool Token
$HPT Huobi Pool Token
 $HT Huobi Token
$HT Huobi Token
 $HYN Hyperion
$HYN Hyperion
 $ICX ICON
$ICX ICON
 $IGNIS Ignis
$IGNIS Ignis
 $ILC ILCoin
$ILC ILCoin
 $INB Insight Chain
$INB Insight Chain
 $INO INO COIN
$INO INO COIN
 $IOST IOST
$IOST IOST
 $IOTX IoTeX
$IOTX IoTeX
 $JUL Joule
$JUL Joule
 $JUP Jupiter
$JUP Jupiter
 $KAN BitKan
$KAN BitKan
 $KBC Karatgold Coin
$KBC Karatgold Coin
 $KCS KuCoin Shares
$KCS KuCoin Shares
 $KICK KickToken
$KICK KickToken
 $KMD Komodo
$KMD Komodo
 $KNC Kyber Network
$KNC Kyber Network
 $LA LATOKEN
$LA LATOKEN
 $LAMB Lambda
$LAMB Lambda
 $LBA Cred
$LBA Cred
 $LEND Aave
$LEND Aave
 $LEO UNUS SED LEO
$LEO UNUS SED LEO
 $LINA Linear Finance
$LINA Linear Finance
 $LINK Chainlink
$LINK Chainlink
 $LOKI Loki
$LOKI Loki
 $LOOM Loom Network
$LOOM Loom Network
 $LRC Loopring
$LRC Loopring
 $LSK Lisk
$LSK Lisk
 $LTC Litecoin
$LTC Litecoin
 $LUNA Terra
$LUNA Terra
 $MAID MaidSafeCoin
$MAID MaidSafeCoin
 $MANA Decentraland
$MANA Decentraland
 $MATIC Matic Network
$MATIC Matic Network
 $MB MineBee
$MB MineBee
 $MCO MCO
$MCO MCO
 $MDA Moeda Loyalty Points
$MDA Moeda Loyalty Points
 $MIN MINDOL
$MIN MINDOL
 $MIOTA IOTA
$MIOTA IOTA
 $MKR Maker
$MKR Maker
 $MOF Molecular Future
$MOF Molecular Future
 $MONA MonaCoin
$MONA MonaCoin
 $MTL Metal
$MTL Metal
 $MX MX Token
$MX MX Token
 $NANO Nano
$NANO Nano
 $NAS Nebulas
$NAS Nebulas
 $NEO Neo
$NEO Neo
 $NET NEXT
$NET NEXT
 $NEW Newton
$NEW Newton
 $NEX Nash Exchange
$NEX Nash Exchange
 $NEXO Nexo
$NEXO Nexo
 $NMR Numeraire
$NMR Numeraire
 $NOAH Noah Coin
$NOAH Noah Coin
 $NPXS Pundi X
$NPXS Pundi X
 $NRG Energi
$NRG Energi
 $NULS NULS
$NULS NULS
 $NXT Nxt
$NXT Nxt
 $OCEAN Ocean Protocol
$OCEAN Ocean Protocol
 $OKB OKB
$OKB OKB
 $OMG OmiseGO
$OMG OmiseGO
 $ONE BigONE Token
$ONE BigONE Token
 $ONE Harmony
$ONE Harmony
 $ONT Ontology
$ONT Ontology
 $PAI Project Pai
$PAI Project Pai
 $PAX Paxos Standard
$PAX Paxos Standard
 $PIVX PIVX
$PIVX PIVX
 $PLC PLATINCOIN
$PLC PLATINCOIN
 $POOLZ Poolz
$POOLZ Poolz
 $POWR Power Ledger
$POWR Power Ledger
 $PPAY PlasmaPay
$PPAY PlasmaPay
 $PPT Populous
$PPT Populous
 $PZM PRIZM
$PZM PRIZM
 $QASH QASH
$QASH QASH
 $QBIT Qubitica
$QBIT Qubitica
 $QC QCash
$QC QCash
 $QNT Quant
$QNT Quant
 $QTUM Qtum
$QTUM Qtum
 $R Revain
$R Revain
 $RCN Ripio Credit Network
$RCN Ripio Credit Network
 $RDD ReddCoin
$RDD ReddCoin
 $REN Ren
$REN Ren
 $REP Augur
$REP Augur
 $RIF RIF Token
$RIF RIF Token
 $RLC iExec RLC
$RLC iExec RLC
 $ROX Robotina
$ROX Robotina
 $RUNE THORChain
$RUNE THORChain
 $RVN Ravencoin
$RVN Ravencoin
 $SAI Single Collateral DAI
$SAI Single Collateral DAI
 $SC Siacoin
$SC Siacoin
 $SEELE Seele
$SEELE Seele
 $SNT Status
$SNT Status
 $SNX Synthetix Network Token
$SNX Synthetix Network Token
 $SOLVE SOLVE
$SOLVE SOLVE
 $STEEM Steem
$STEEM Steem
 $STORJ Storj
$STORJ Storj
 $STRAT Stratis
$STRAT Stratis
 $STREAM Streamit Coin
$STREAM Streamit Coin
 $STX Blockstack
$STX Blockstack
 $SXP Swipe
$SXP Swipe
 $SYS Syscoin
$SYS Syscoin
 $TAGZ5 TAGZ5
$TAGZ5 TAGZ5
 $THETA THETA
$THETA THETA
 $THR ThoreCoin
$THR ThoreCoin
 $THX ThoreNext
$THX ThoreNext
 $TNT Tierion
$TNT Tierion
 $TOMO TomoChain
$TOMO TomoChain
 $TRAT Tratin
$TRAT Tratin
 $TRUE TrueChain
$TRUE TrueChain
 $TRX TRON
$TRX TRON
 $TT Thunder Token
$TT Thunder Token
 $TUSD TrueUSD
$TUSD TrueUSD
 $UBT Unibright
$UBT Unibright
 $USDC USD Coin
$USDC USD Coin
 $USDK USDK
$USDK USDK
 $USDT Tether
$USDT Tether
 $VEST VestChain
$VEST VestChain
 $VET VeChain
$VET VeChain
 $VITAE Vitae
$VITAE Vitae
 $VLX Velas
$VLX Velas
 $VSYS V Systems
$VSYS V Systems
 $VTC Vertcoin
$VTC Vertcoin
 $WAN Wanchain
$WAN Wanchain
 $WAVES Waves
$WAVES Waves
 $WAXP WAX
$WAXP WAX
 $WICC WaykiChain
$WICC WaykiChain
 $WIN WINk
$WIN WINk
 $WTC Waltonchain
$WTC Waltonchain
 $WXT Wirex Token
$WXT Wirex Token
 $XEM NEM
$XEM NEM
 $XET ETERNAL TOKEN
$XET ETERNAL TOKEN
 $XIN Mixin
$XIN Mixin
 $XLM Stellar
$XLM Stellar
 $XMR Monero
$XMR Monero
 $XMX XMax
$XMX XMax
 $XRP XRP
$XRP XRP
 $XTP Tap
$XTP Tap
 $XTZ Tezos
$XTZ Tezos
 $XVG Verge
$XVG Verge
 $XZC Zcoin
$XZC Zcoin
 $YAP Yap Stone
$YAP Yap Stone
 $YOU YOU COIN
$YOU YOU COIN
 $ZB ZB Token
$ZB ZB Token
 $ZEC Zcash
$ZEC Zcash
 $ZEN Horizen
$ZEN Horizen
 $ZIL Zilliqa
$ZIL Zilliqa
 $ZRX 0x
$ZRX 0x
 Binance
Binance
 Bittrex
Bittrex
 HitBTC
HitBTC
 Huobi
Huobi
 Kraken
Kraken
 Kucoin
Kucoin
✗ Close categories
✗ Close categories
-
Man sentenced in 2017 rollover crash that killed his passenger
via post-gazette.com Jesse Schuckert, 27, was sentenced to two years in prison and 12 years probation for the crash that killed McKenzi Loid.
Jesse Schuckert, 27, was sentenced to two years in prison and 12 years probation for the crash that killed McKenzi Loid. -
Cheron Shelton, Found Not Guilty In Wilkinsburg Mass Shooting Trial, Charged With Illegally Possessing Rife, Ammunition
 WILKINSBURG, Pa. (KDKA) — The man found not guilty in the Wilkinsburg mass shooting trial has been charged with illegally possessing a rifle and ammunition.
WILKINSBURG, Pa. (KDKA) — The man found not guilty in the Wilkinsburg mass shooting trial has been charged with illegally possessing a rifle and ammunition.
The Department of Justice announced Cheron Shelton was indicted by a federal grand jury on a charge of violating federal firearms laws, announced Tuesday.
The indictment says on March 12, 2016 that Shelton possed a Colt Model M4, a .22 caliber rifle, knowing that he had been previously convicted of a crime.
Shelton was the lone defenda -
Post Malone Wears ‘RIP Mac Miller’ Shirt During Pittsburgh Concert
 PITTSBURGH (KDKA) – Post Malone wore a shirt that said “RIP Mac Miller” to honor the late Pittsburgh rapper while he played a show in Pittsburgh Monday night.On Twitter, the Mac Miller Memoir posted a photo of Post Malone wearing a “RIP Mac Miller” shirt. Post Malone was at PPG Paints Arena for the second leg of his “Runaway Tour.”Last night in Pittsburgh @PostMalone was wearing his RIP Mac Miller shirt pic.twitter.com/a8DSJ6m0vm
PITTSBURGH (KDKA) – Post Malone wore a shirt that said “RIP Mac Miller” to honor the late Pittsburgh rapper while he played a show in Pittsburgh Monday night.On Twitter, the Mac Miller Memoir posted a photo of Post Malone wearing a “RIP Mac Miller” shirt. Post Malone was at PPG Paints Arena for the second leg of his “Runaway Tour.”Last night in Pittsburgh @PostMalone was wearing his RIP Mac Miller shirt pic.twitter.com/a8DSJ6m0vm
— The Mac Miller M -
Uniontown funeral director sent to prison in fraud case
via post-gazette.com Stephen E. Kezmarsky III will also have to pay more than a half-million dollars in restitution for scamming more than 80 victims.
Stephen E. Kezmarsky III will also have to pay more than a half-million dollars in restitution for scamming more than 80 victims. -
Former Uniontown funeral director sent to prison in fraud case
via post-gazette.com Stephen E. Kezmarsky III will also have to pay more than a half-million dollars in restitution for scamming more than 80 victims.
Stephen E. Kezmarsky III will also have to pay more than a half-million dollars in restitution for scamming more than 80 victims. -
Audit: School Administrators Allegedly Spent $700,000 On Strip Clubs, Booze, Online Gaming
 MONTGOMERY, Ala. (CBS Local) — An audit of an Alabama school district shows administrators allegedly misused more than $700,000 of public money on strip clubs, liquor stores, nonexistent vendors and scholarships for an administrator’s children.
MONTGOMERY, Ala. (CBS Local) — An audit of an Alabama school district shows administrators allegedly misused more than $700,000 of public money on strip clubs, liquor stores, nonexistent vendors and scholarships for an administrator’s children.
In total, six former and current employees of Montgomery Public Schools were named in connection with $703,297.66 that was claimed as misused or missing between October 2017 and September 2018, CBS affiliate WAKA reported.
Walter James, the fo -
Pennsylvania will take part in multi-state investigation of Juul
via post-gazette.com Angered with an epidemic of teenage vaping, attorneys general from 39 states say they will cooperate in an investigation into vaping company Juul
Angered with an epidemic of teenage vaping, attorneys general from 39 states say they will cooperate in an investigation into vaping company Juul -
Man Convicted Of 1st-Degree Murder For Shooting, Killing Another Man In Spring Garden
 SPRING GARDEN (KDKA) — A man was found guilty of murdering another man in Spring Garden.
SPRING GARDEN (KDKA) — A man was found guilty of murdering another man in Spring Garden.
A judge convicted Justin Parrotte on Tuesday of first-degree murder for the killing of John Miller.
Using surveillance video and a statement from a witness, police identified the 28-year-old Parrotte as a suspect.
Miller, 40, was found at the bottom of a set of city steps in the 1000 block of Vinial Street in 2017.
According to the medical examiner, Miller suffered gunshot wounds to the head, trunk and -
Man Charged With Homicide By Vehicle While Driving Under The Influence Following Deadly Hampton Township Crash
 HAMPTON TOWNSHIP (KDKA) — A man is charged with homicide by vehicle while driving under the influence following a two-vehicle crash that killed one in Hampton Township.
HAMPTON TOWNSHIP (KDKA) — A man is charged with homicide by vehicle while driving under the influence following a two-vehicle crash that killed one in Hampton Township.
On Tuesday, 32-year-old Carl John Keating was arrested and charged, Allegheny County announced.
In December 2019, officials say a 28-year-old Rebecca Koorsen passenger was killed after the northbound vehicle she was in crossed the southbound lanes on Route 8 and was struck by a southbound vehicle.
There were no other vehicl -
Kidsburgh Kidcast: Jeremiah’s Place
 PITTSBURGH (KDKA) – Finding childcare in a crisis, emergency or at the last minute can be a huge challenge. That’s why Jeremiah’s Place opened — Pittsburgh’s only crisis nursery.
PITTSBURGH (KDKA) – Finding childcare in a crisis, emergency or at the last minute can be a huge challenge. That’s why Jeremiah’s Place opened — Pittsburgh’s only crisis nursery.
Kristine Sorensen talks with Jeremiah’s Place Executive Director Lisa Perry about what the center offers and the kinds of reason a parent or caregiver can use their free service.Here’s their edited conversation.
Kristine Sorensen:What is Jeremiah’s Place?
Lisa Perry: We ar -
Spring Training Report: White Sox’ Luis Robert, Other Possible Future All-Stars Take Field
 CHICAGO (CBS) — Spring Training offers a fresh start around MLB, insofar as that’s possible with baseball working through the aftermath of the Houston Astros cheating scandal. The exhibition games have started. And while they mean nothing in terms of the standings, they can mean a lot for players’ futures.
CHICAGO (CBS) — Spring Training offers a fresh start around MLB, insofar as that’s possible with baseball working through the aftermath of the Houston Astros cheating scandal. The exhibition games have started. And while they mean nothing in terms of the standings, they can mean a lot for players’ futures.
The league’s prominent up-and-comers have an opportunity to secure their places on opening day rosters or at least make their case for a call-up in the weeks -
Judge Denies Prosecutors’ Motion To Impose Mental Health Deadlines In Tree Of Life Shooting Case
 PITTSBURGH (KDKA) – The judge in the capital murder case against the accused Tree of Life shooter denied the prosecutions’ motion to set a deadline for mental health evaluations.
PITTSBURGH (KDKA) – The judge in the capital murder case against the accused Tree of Life shooter denied the prosecutions’ motion to set a deadline for mental health evaluations.
The judge gave Robert Bowers’ defense team four more months to decide if it wants to use mental health evidence at the trial.
The U.S. Attorney wanted all mental evaluations for Robert Bowers to be completed by April 23.
Judge Donetta Ambrose set a meeting for June 25 and said all attorneys will discus -
Legionnaires' case prompts cautious county to test water
via post-gazette.com A county employee tested positive for Legionnaires’ disease, prompting the county to test the water in the building where the employee works
A county employee tested positive for Legionnaires’ disease, prompting the county to test the water in the building where the employee works -
‘That Is My Baby!’: Teen’s Mom Discovers Son’s Good Deed On Social Media
 CINCINNATI (WXIX/Gray News) — The mother of an Ohio high school student says she didn’t know her son regularly helps a blind woman cross the street until an image of them was shared on social media.
CINCINNATI (WXIX/Gray News) — The mother of an Ohio high school student says she didn’t know her son regularly helps a blind woman cross the street until an image of them was shared on social media.
The picture shows Dontarius Caldwell, a 15-year-old freshman at Aiken High School, walking a visually impaired woman across Hamilton Avenue and then across North Bend Road in Cincinnati.
“Just thought man that is the coolest thing I’ve ever seen. When they stopped at that corn -
5 People Hurt After Megabus Headed From Pittsburgh To New York Crashes Into Tractor Trailer
 BLAIRSTOWN TOWNSHIP, N.J. (KDKA) — Five people were injured when a Megabus heading from Pittsburgh to New York City struck a tractor trailer in New Jersey early Tuesday morning.
BLAIRSTOWN TOWNSHIP, N.J. (KDKA) — Five people were injured when a Megabus heading from Pittsburgh to New York City struck a tractor trailer in New Jersey early Tuesday morning.
According to state police in New Jersey, the crash happened just after 5:30 a.m. on the eastbound side of Interstate 80 in Blairstown Township, Warren County, New Jersey.
State police say the Megabus hit the rear of the tractor trailer, shattering the windshield.
(Source: Hope Volunteer Fire Department – Stat -
Westmoreland Co. Teen Who Was 14 When He Killed Mom, Brother Pleads Guilty But Mentally Ill
 GREENSBURG, Pa. (AP) — A western Pennsylvania man has been sentenced to two concurrent prison terms of 30 years to life in the slayings of his mother and younger brother more than three years ago when he was 14 years old.
GREENSBURG, Pa. (AP) — A western Pennsylvania man has been sentenced to two concurrent prison terms of 30 years to life in the slayings of his mother and younger brother more than three years ago when he was 14 years old.
The Tribune Review reports that now-18-year-old Jacob Remaley apologized Tuesday in Westmoreland County Court as he pleaded guilty but mentally ill to the charges, saying “I know I am guilty.”
(Photo Source: Facebook)
Public defender Wayne McGrew had said in O -
Warm Weather Getaways Help Beat The Winter Blues
 PITTSBURGH (KDKA) — If the cold weather has got you down, check out some of these ways to save money on warm getaways.
PITTSBURGH (KDKA) — If the cold weather has got you down, check out some of these ways to save money on warm getaways.
Rick Sicilio, of Classic Travel and Tours, stopped into Pittsburgh Today Live to talk with Heather and David about some destinations to consider if you’re trying to escape Pittsburgh’s gloomy weather.
Sicilio talked about how cruises look at the springtime as “Wave Season” when they give big discounts. “Wave Season” takes place between J -
‘Motivated By Abject Greed’: Funeral Home Director Going To Prison For Ripping Off Elderly Customers
 UNIONTOWN (KDKA) — A Fayette County funeral director is going to prison after pleading guilty to ripping off elderly customers.
UNIONTOWN (KDKA) — A Fayette County funeral director is going to prison after pleading guilty to ripping off elderly customers.
Stephen Kezmarsky, 51, the owner of Kezmarsky Funeral Home in Uniontown, has been sentenced to eight years in prison and 20 years of probation.
(Photo Credit: KDKA)
Last October, Kezmarsky pleaded guilty to charges of theft and forgery.
In total, he entered a guilty plea for 172 counts. Investigators say he stole more than $500,000.Fayette county judge Steve P. Le -
Former Pittsburgh Steelers Head Coach Bill Cowher Visits Pro Football Hall Of Fame Ahead Of His Induction
 CANTON (KDKA) — Bill Cowher is visiting the hallowed grounds of the Pro Football Hall Of Fame ahead of his induction in August.Cowher joined fellow inductee Issac Bruce at the facility Tuesday, where he toured the Hall and spoke to the media.“In Canton Ohio to speak with Hall of Famer @CowherCBS tonight @KDKA”In Canton Ohio to speak with Hall of Famer @CowherCBStonight @KDKA pic.twitter.com/EfBydclBb3
CANTON (KDKA) — Bill Cowher is visiting the hallowed grounds of the Pro Football Hall Of Fame ahead of his induction in August.Cowher joined fellow inductee Issac Bruce at the facility Tuesday, where he toured the Hall and spoke to the media.“In Canton Ohio to speak with Hall of Famer @CowherCBS tonight @KDKA”In Canton Ohio to speak with Hall of Famer @CowherCBStonight @KDKA pic.twitter.com/EfBydclBb3
— Bob Pompeani (@KDPomp) Febr -
Oakmont Bakery Celebrates Mardi Gras With Traditional Treats
 PITTSBURGH (KDKA) — Local Pittsburgh bakery, Oakmont Bakery, is serving up some Mardi Gras treats for the holiday.
PITTSBURGH (KDKA) — Local Pittsburgh bakery, Oakmont Bakery, is serving up some Mardi Gras treats for the holiday.
Pittsburgh Today Live’s Celina Pompeani visited Oakmont Bakery to get to work on prepping some treats for PTL’s Fat Tuesday.
Customers were all lined up to receive their Fat Tuesday goodies before the beginning of Lent.
Two customers in particular, Joyce and Don, made the drive from Saxonburg to pick up their pastries.
Part 2:
Celina met with Father and Son Owners -
Judge convicts man in 2017 slaying on city steps in Spring Garden
via post-gazette.com Police said Justin Parrotte thought the victim, John Miller, might have relayed information to police resulting in a drug bust.
Police said Justin Parrotte thought the victim, John Miller, might have relayed information to police resulting in a drug bust. -
Vincentian Academy to close at end of school year
via post-gazette.com The Sisters of Charity of Nazareth, which runs the school, announced the decision to close Tuesday morning.
The Sisters of Charity of Nazareth, which runs the school, announced the decision to close Tuesday morning. -
Overturned Tractor Trailer Shuts Down Road, Rail Traffic In South Hills
 BALDWIN (KDKA) — A major crash involving an overturned vehicle has shut down a busy road, as well as railroad traffic, in Baldwin Borough this afternoon.
BALDWIN (KDKA) — A major crash involving an overturned vehicle has shut down a busy road, as well as railroad traffic, in Baldwin Borough this afternoon.
According to Allegheny County, the tractor trailer overturned on railroad tracks just before noon in the 1600 block of Streets Run Road.
The tractor trailer is leaking diesel fuel.
There is a heavy presence of emergency workers on the scene.Baldwin Borough: Vehicle crash – 1600 Blk Streets Run Rd; Responders on scene of overturned v -
Overturned Tractor Trailer Shut Down Road, Rail Traffic In South Hills
 WEST MIFFLIN (KDKA) — A major crash involving an overturned vehicle temporarily shut down a busy road, as well as railroad traffic, in West Mifflin this afternoon.
WEST MIFFLIN (KDKA) — A major crash involving an overturned vehicle temporarily shut down a busy road, as well as railroad traffic, in West Mifflin this afternoon.
According to Allegheny County, the tractor trailer overturned near railroad tracks just before noon in the 1600 block of Streets Run Road.
Police say the load of steel the tractor trailer was hauling shifted, sending it onto its side on the curve across the tracks.Streets Run closed due to Truck overturning on the RR tracks at P -
‘It’s Not Your Typical Legal Show’: Simone Missick On CBS’s ‘All Rise’ & Netflix’s ‘Altered Carbon’
 (CBS Local)– Simone Missick’s rise to stardom was a slow burn, but things are starting to happen for the Michigan native.
(CBS Local)– Simone Missick’s rise to stardom was a slow burn, but things are starting to happen for the Michigan native.
Missick is the lead on CBS’s new legal drama “All Rise” and will be popping into season two of Netflix’s “Altered Carbon” with Anthony Mackie. While many know the actor for her work as superhero Misty Knight, Missick is proud to be playing a judge on network television.
“The best part for me has been the fans,” -
“I’m Encouraged And Excited” Pittsburgh Steelers GM Kevin Colbert Says Ben Roethlisberger Could Be A Better Player Post-Surgery
 INDIANAPOLIS (KDKA)– General Manager Kevin Colbert thinks that this could be a very special football season for his staring quarterback.“Kevin Colbert at the podium at #NFLCombine @KDKA”Kevin Colbert at the podium at #NFLCombine @KDKA pic.twitter.com/Lak63u3Yvm
INDIANAPOLIS (KDKA)– General Manager Kevin Colbert thinks that this could be a very special football season for his staring quarterback.“Kevin Colbert at the podium at #NFLCombine @KDKA”Kevin Colbert at the podium at #NFLCombine @KDKA pic.twitter.com/Lak63u3Yvm
— Rich Walsh KDKA (@RichieWalsh) February 25, 2020Colbert said Ben Roethlisberger, who missed most of 2019 with a major elbow injury that required surgery and months of recovery time, could very well be better off -
Vincentian Academy Closing Due to Declining Enrollment, Financial Issues
 ROSS TOWNSHIP (KDKA) — A private high school in the North Hills will be closing its doors at the end of the school year due to a number of challenges.
ROSS TOWNSHIP (KDKA) — A private high school in the North Hills will be closing its doors at the end of the school year due to a number of challenges.
The Sisters of Charity of Nazareth say they will be closing Vincentian Academy after the 2019-2020 school year due to declining enrollment and increasing financial losses.
Stay with KDKA for the latest on this developing story. -
‘The Door Is Always Open,’ Pittsburgh Steelers GM Kevin Colbert Says Team Checked In On Antonio Brown’s Well-Being
 INDIANAPOLIS (KDKA) — Steelers General Manager Kevin Colbert says the team will always be there to support Antonio Brown.
INDIANAPOLIS (KDKA) — Steelers General Manager Kevin Colbert says the team will always be there to support Antonio Brown.
Colbert spoke at the NFL Combine at Lucas Oil Stadium in Indianapolis Tuesday morning and addressed a myriad of topics from national media members.He made it clear that the Steelers will always be there in support for Antonio Brown as a person. Colbert said the team had reached out to his representatives to check in on him while he was going through some of the rougher -
Freshman Student Joshua Stanley Reported Missing From Penn College
 WILLIAMSPORT (KDKA) — Friends and family are searching for Joshua Lane Stanley, a Penn College student who is missing.
WILLIAMSPORT (KDKA) — Friends and family are searching for Joshua Lane Stanley, a Penn College student who is missing.
NorthcentralPa.com reports that Stanley went missing Sunday evening.Despite having a vehicle on campus, Stanley reportedly left the campus on foot, saying he was going to meet a friend.Photo Credit: NorthcentralPa.com
Tiadaghton Police Department reportedly received a call from a concerned citizen saying that they had seen a man walking in the road along Rt. 44 near Jersey -
AIU selects new executive director
via post-gazette.com Robert Scherrer, the superintendent of the North Allegheny School District, will take over the regional public education agency on July 20.
Robert Scherrer, the superintendent of the North Allegheny School District, will take over the regional public education agency on July 20. -
Beauty professionals to bankers turn out for Pittsburgh's first fashion summit
via post-gazette.com The inaugural Pittsburgh Fashion Summit attracted a range of business professionals and rising fashion talents to the Union Trust Building.
The inaugural Pittsburgh Fashion Summit attracted a range of business professionals and rising fashion talents to the Union Trust Building. -
UPDATE: State police say missing Armstrong County teen has been located
via post-gazette.com The girl, Melissa Erin Dunkle, was last seen Monday afternoon at her family home in Parker.
The girl, Melissa Erin Dunkle, was last seen Monday afternoon at her family home in Parker. -
State police seek missing Armstrong County girl, 13
via post-gazette.com The girl, Melissa Erin Dunkle, was last seen Monday afternoon at her family home in Parker.
The girl, Melissa Erin Dunkle, was last seen Monday afternoon at her family home in Parker. -
Joe Rogan To Perform Show At PPG Paints Arena In May
 PITTSBURGH (KDKA) — Joe Rogan and his Sacred Clown Tour will be making a stop in Pittsburgh in May.
PITTSBURGH (KDKA) — Joe Rogan and his Sacred Clown Tour will be making a stop in Pittsburgh in May.
Rogan will be performing at PPG Paints Arena on Saturday, May 16th, 2020.JUST ANNOUNCED: Comedian Joe Roganis bringing his Sacred Clown tour to PPG Paints Arena on Saturday, May 16th!! Tickets go on sale this Friday, February 28th at 10 am. Don’t miss a night of laughs with Joe Rogan’s LIVE stand-up pic.twitter.com/Tc6LTaMUIs
— PPG Paints Arena (@PPGPaintsArena) February 25 -
Pa. State Police Searching For Missing 13-Year Old, Melissa Dunkle
 PARKER, Pa. (KDKA) — Pennsylvania State Police are asking for help locating a missing teenager.
PARKER, Pa. (KDKA) — Pennsylvania State Police are asking for help locating a missing teenager.
13-year old Melissa Dunkle was last seen by her family at their home in Parker City on February 24th, 2020 at 4:00 p.m.
(Courtesy: Pennsylvania State Police)
She is considered a missing juvenile.
Anyone with information of her whereabouts is asked to contact the State Police’s Butler Crime Unit at 724-284-8100.
-
Pa. State Police Locate Missing 13-Year Old
 PARKER, Pa. (KDKA) — Pennsylvania State Police have located a missing teenager.
PARKER, Pa. (KDKA) — Pennsylvania State Police have located a missing teenager.
13-year old Melissa Dunkle was reported missing by Pennsylvania State Police.
She has since been located.***LOCATED***
This juvenile has been located. https://t.co/gI5QLnkJBm
— Troopers Kesten, Black and Long (@PSPTroopDPIO) February 25, 2020 -
Santana To Play Summer Concert With Earth, Wind, And Fire At S & T Bank Music Park
 BURGETTSTOWN (KDKA) — Santana and Earth, Wind, and Fire will be making a stop in the Pittsburgh area this coming summer.
BURGETTSTOWN (KDKA) — Santana and Earth, Wind, and Fire will be making a stop in the Pittsburgh area this coming summer.
The two groups will be playing at S & T Bank Music Park on August 5th, 2020 as part of their Miraculous Supernatural 2020 Tour.JUST ANNOUNCED: @SantanaCarlos and @EarthWindFire are bringing the Miraculous Supernatural 2020 tour to Burgettstown on August 5th! Presales start 2/27 at 10am local.
Get more info here: https://t.co/X9aVOwW8aH pic.twitter.com/edVWaTXtQ9
&mda -
The dough of East Liberty's "Pizza Row"
via post-gazette.com Five pizzerias along six blocks of Highland Avenue in East Liberty bridge the neighborhood’s past with its present day.
Five pizzerias along six blocks of Highland Avenue in East Liberty bridge the neighborhood’s past with its present day. -
Slices of Life: The dough of East Liberty's "Pizza Row"
via post-gazette.com Five pizzerias along six blocks of Highland Avenue in East Liberty bridge the neighborhood’s past with its present day.
Five pizzerias along six blocks of Highland Avenue in East Liberty bridge the neighborhood’s past with its present day. -
PTL Links: February 25, 2020
 Visit the links below for more on today’s guests & topics:Oakmont Bakery
Visit the links below for more on today’s guests & topics:Oakmont Bakery
Classic Travel and Tours
The Mall At Robinson
PTL Puppy Penguin on Facebook
PTL Puppy Penguin on Twitter
Canine Companions for Independence on InstagramPittsburgh Today Live On Social Media:Facebook
Twitter
Instagram -
Possible Whooping Cough Exposure Investigated At Bethel Park High School
 BETHEL PARK (KDKA) — Students at Bethel Park High School may have been exposed to whooping cough.
BETHEL PARK (KDKA) — Students at Bethel Park High School may have been exposed to whooping cough.
In a letter sent home to families, Bethel Park High School Principal Dr. Zeb Jansante informed parents and guardians of the possible exposure to students.
(Photo Credit: KDKA)
The symptoms can appear anywhere from five days to three weeks after infection. It starts off like a common cold, followed by a cough that gets worse over one to two weeks.According to the Center for Disease Control and -
Possible Whooping Cough Exposure At Bethel Park High School
 BETHEL PARK, Pa. (KDKA) — Students at Bethel Park High School may have been exposed to whooping cough.
BETHEL PARK, Pa. (KDKA) — Students at Bethel Park High School may have been exposed to whooping cough.
In a letter, Bethel Park Principal Dr. Zeb Jansante informed parents and guardians of the possible exposure to students.
“Whooping cough, also called pertussis, is a very contagious bacterial infection that can spread through close contact when people with the disease cough. Symptoms can appear 5 to 21 days after infection. It usually starts like a common cold (e.g., sneezing, runny -
Grocery Store Owner Admits Stealing Thousands In Coupon Scam
 PITTSBURGH (AP) — The owner of four Pittsburgh area grocery stores has admitted pocketing hundreds of thousands of dollars by claiming customers used coupons he had employees take out of unsold newspapers.
PITTSBURGH (AP) — The owner of four Pittsburgh area grocery stores has admitted pocketing hundreds of thousands of dollars by claiming customers used coupons he had employees take out of unsold newspapers.
Michael Mihelic pleaded guilty Monday to theft by deception and was sentenced to four years of probation.
Authorities said the 60-year-old Franklin Park man made roughly $300,000 through the scam but has already paid $275,895 in restitution.
Mihelic directed staff at his four Shop &lsquo -
Crews Respond To Playground To Free Teenager Stuck In Toddler Swing
 INDIANA, Pa. (KDKA) — A teenager needed to call 911 for help after getting stuck in a toddler swing at a playground.
INDIANA, Pa. (KDKA) — A teenager needed to call 911 for help after getting stuck in a toddler swing at a playground.
According to a Facebook post from the Indiana Fire Association, the Rescue Squad was dispatched Monday evening to a local park for a teenager stuck in a toddler swing.
The teen had tried to sit in the swing and it had become to tight around the thighs.
After being unable to free themselves, they called 911.
Responding crews had the teen stand on a garbage can to relieve the -
Police Warn Public Of Money Order Scam
 SOUTH PARK TOWNSHIP (KDKA) — A local police department is urging residents to exercise caution in regard to an ongoing scam.
SOUTH PARK TOWNSHIP (KDKA) — A local police department is urging residents to exercise caution in regard to an ongoing scam.
South Park Township Police have received reports from some residents about a postal money order scam.
In this scam, potential targets are receiving documents in the mail.
(Courtesy: South Park Township Police)
These documents are instructing the target to deposit a postal money order into their bank and then purchase some gift cards and call the codes in.
A few days -
Workplaces make an effort to accommodate nursing mothers
via post-gazette.com Businesses in the Pittsburgh region have found different solutions to accommodating new mothers who wish to take time to pump breast milk.
Businesses in the Pittsburgh region have found different solutions to accommodating new mothers who wish to take time to pump breast milk. -
Tree of Life shooting part of documentary 'Viral: Antisemitism in Four Mutations"
via post-gazette.com Film will screen at AMC Waterfront beginning February 28
Film will screen at AMC Waterfront beginning February 28 -
Muffy Mendoza helps cultivate safe space for black mothers in Pittsburgh and beyond
via post-gazette.com The Sheraden resident has cultivated a supportive resource community of more than 5,000 African American moms in Pittsburgh and across the country. Being a mother is a “thankless job,” she said.
The Sheraden resident has cultivated a supportive resource community of more than 5,000 African American moms in Pittsburgh and across the country. Being a mother is a “thankless job,” she said. -
Pittsburgh Weather: Rain And Snow On The Way
 PITTSBURGH (KDKA) — Spotty rain showers are expected throughout the day today.
PITTSBURGH (KDKA) — Spotty rain showers are expected throughout the day today.
While a big chunk of Wednesday will be dry, rain showers are expected to be back for the afternoon with some moderate rain showers working their way through the area.
The rain will change over to snow late in the day on Wednesday with snow showers expected to continue in some spots throughout the overnight hours.Latest numbers from the forecast models are pointing to a decent amount of snow falling, with up to t -
Local Bakeries Working Overtime To Prepare For Fat Tuesday
 BROOKLINE (KDKA) — At Party Cake Shop in Brookline, bakers have been preparing all night for Fat Tuesday.
BROOKLINE (KDKA) — At Party Cake Shop in Brookline, bakers have been preparing all night for Fat Tuesday.
Early Tuesday morning, they were working on donuts before switching back to Pączki.
The owners of the bakery told KDKA’s Nicole Ford that they’ve already made 297 dozen of the pastries.
They say they will make 240 more, for a grand total of 6,444 Pączki.I’m dying just staring all the sugar!!! Plus I’m getting a history lesson on the meaning behind Mard
01 Mar 202029 Feb 202028 Feb 202027 Feb 202026 Feb 202024 Feb 202023 Feb 202022 Feb 202021 Feb 202020 Feb 2020
Follow @PittsburghNews_ on Twitter!

